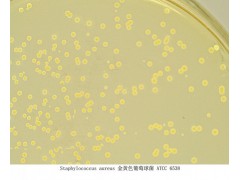

用 途:
用于細菌總數測定(GB 4789.2-2010,SN0168-92和GB13093-91)。
原 理:
胰蛋白胨提供碳源和氮源;酵母膏粉提供B族維生素;葡萄糖提供能源;瓊脂是培養基的凝固劑。
配方(每升):
|
胰蛋白胨
|
5.0g
|
|
酵母膏粉
|
2.5g
|
|
葡萄糖
|
1.0g
|
|
瓊脂
|
15.0g
|
最終pH 7.0±0.2
使用方法:
1、 稱取本品23.5g,加入蒸餾水或去離子水1 L,攪拌加熱煮沸至完全溶解,分裝三角瓶,121℃高壓滅菌15min,備用。
2、 樣品的稀釋及處理,略。
3、 根據商檢的標準要求或對標本污染情況的估計,選擇2—3個稀釋度,分別在10倍遞增稀釋的同時,即以吸取該稀釋度的吸管移1mL稀釋液于滅菌平皿內,每個稀釋度做兩個平皿。
4、 稀釋液移入平皿后,應及時將涼至45℃的瓊脂培養基(可放置于45℃水浴箱保溫)注入平皿約15mL,并轉動平皿使混合均勻。同時將瓊脂培養基傾入加有1mL稀釋液的滅菌平皿內作空白對照。
5、 待瓊脂凝固后,翻轉平板,置36±1℃溫箱內培養48±2h。
6、 觀察結果并進行計數。25-250個菌落為合適范圍。
質量控制:
下列菌株在本培養基平板上,36±1℃培養48±2h后 ,結果如下:
|
菌 名 菌 號 生長狀況 菌落
|
|
大腸埃希氏菌 ATCC25922 良好 白色—灰白色
金黃色葡萄球菌 ATCC6538 良好 黃色
|
貯 存:貯存于避光、陰涼干燥處。
規 格:250g
參考文獻:
SN0168-92 中華人民共和國進出口商品檢驗行業標準出口食品平板菌落計數
SN0168-92 中華人民共和國進出口商品檢驗行業標準出口食品平板菌落計數
GB13093-91 中華人民共和國國家標準 飼料中細菌總數的測定方法